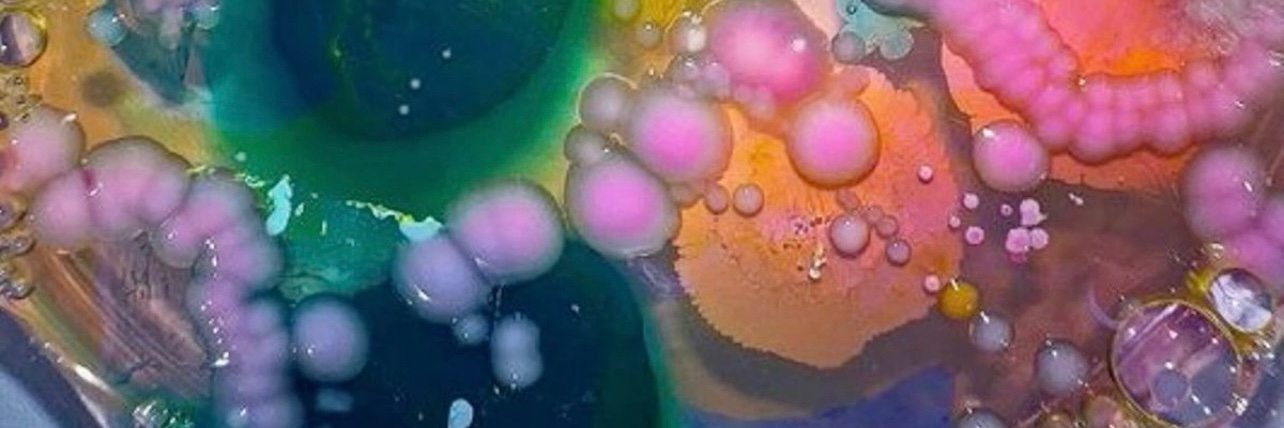
kkyay banner

Sabitlenmiş Tweet

🚨ATTENTION🚨
I will be opening my commissions for the first time in a while, please dm me if you are interested. Any support is greatly appreciated! I need another way to make money and am newer to commissioning, please be mindful and patient! Thank you‼️
ko-fi.com/kkyay


English